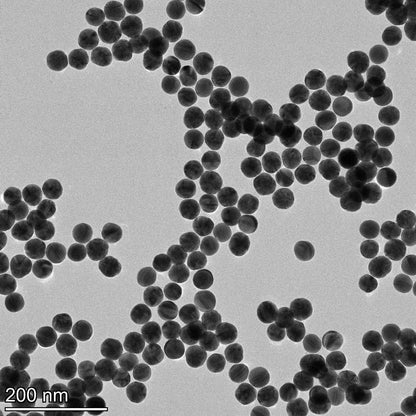
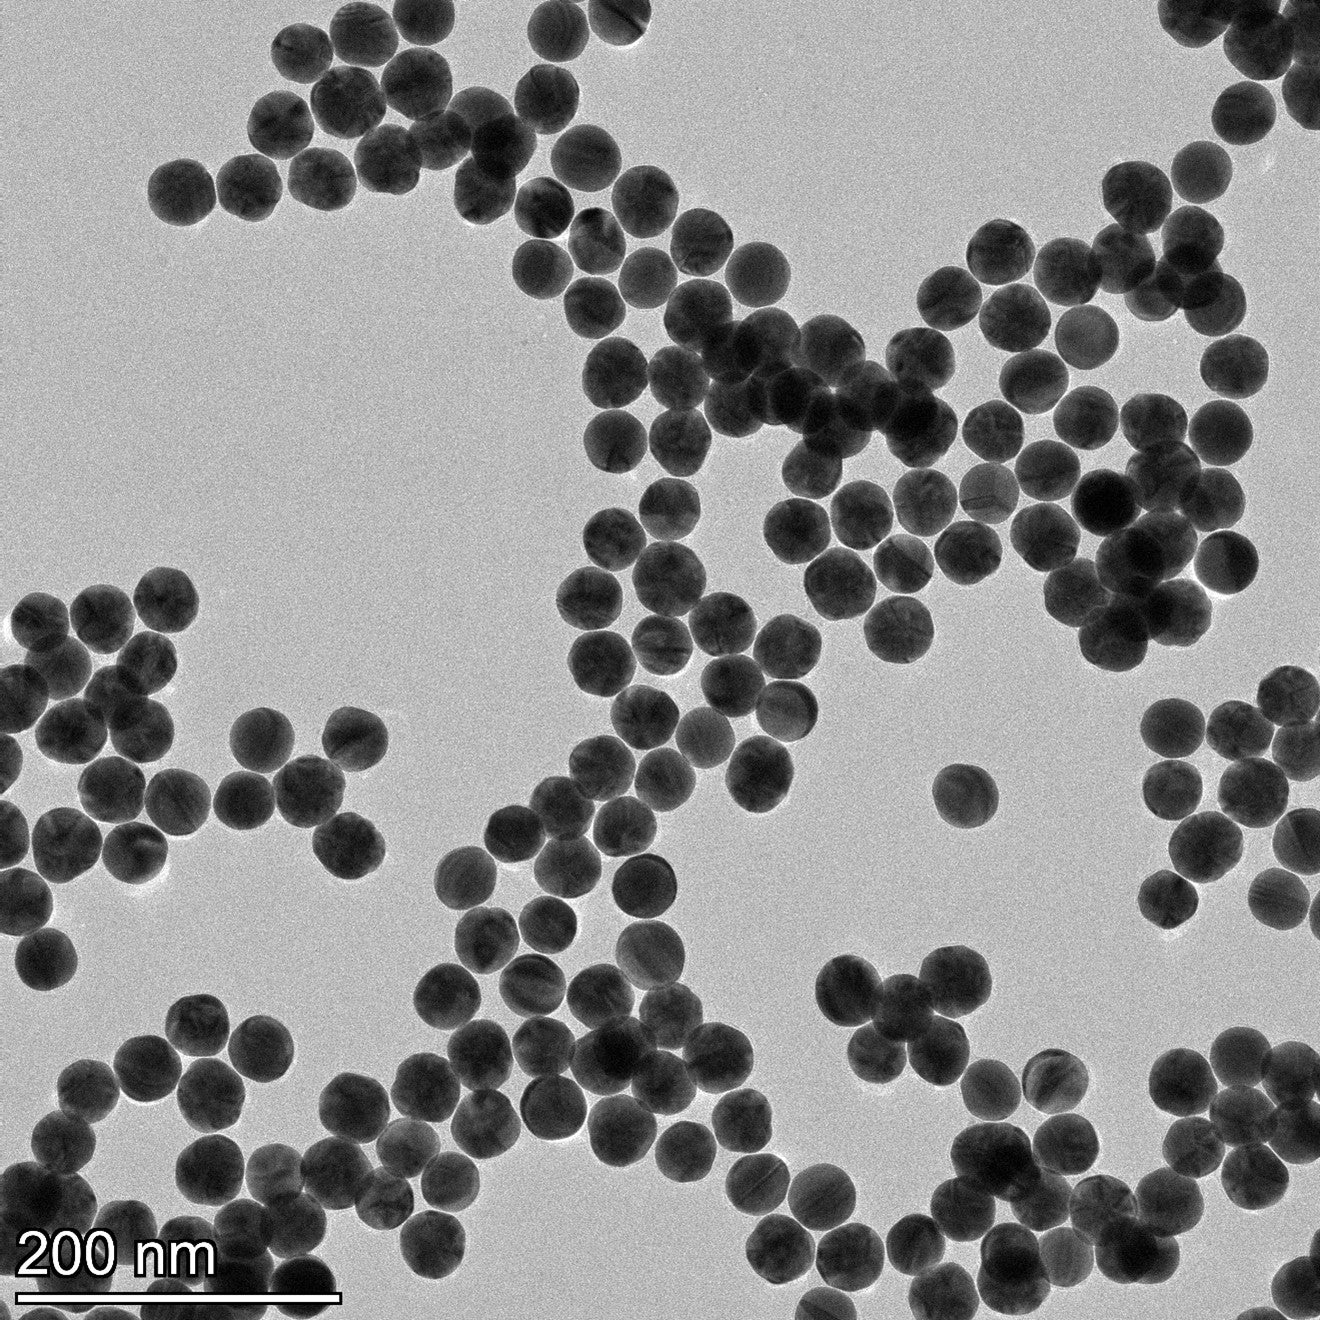
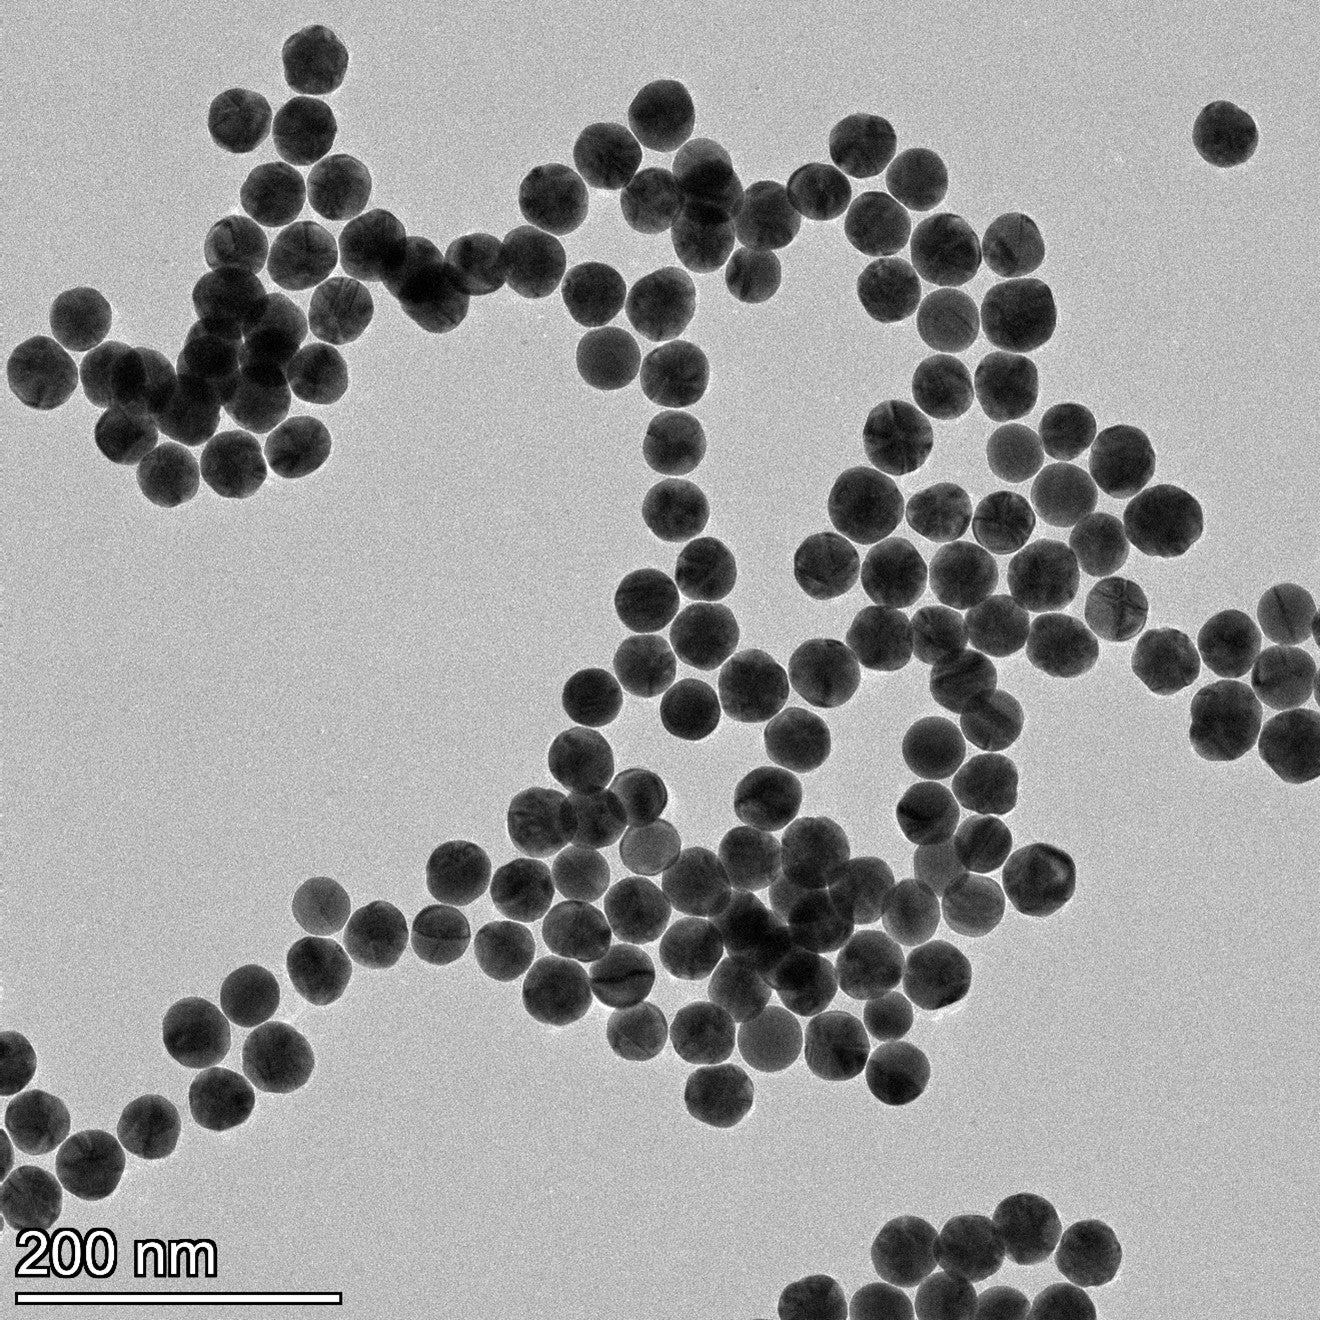

Ma boutique
40 nm Gold Nano-Spheres
40 nm Gold Nano-Spheres
SKU:SKU: NB-GSP-40-CIT-1-10
Couldn't load pickup availability
Spherical Gold Nanoparticles manufactured by NanoBrand offer several key advantages for Life Science applications:
High monodispersity:
- CoV (Coefficient of variation/polydispersity) ≤ 5% (with CoV ≤ 12-15% offered on the market) for particles of 10nm size and larger,
- Polydispersity index (PdI) ≤ 0.1 (with PdI≤ 0.2 typically available).
The high monodispersity ensures uniform properties across the nanoparticle population, leading to more reliable and reproducible experimental results.
Consistent optical properties: The uniform size distribution results in consistent and predictable optical properties, crucial for many sensing and imaging applications.
Absence of additional stabilizing agents: Our nanoparticles are dispersed in Milli-Q water (18.1 MΩ-cm) and have long-term dispersion stabilities, without any need for additional stabilizers, which may be potentially interfering. Alternatively, the nanoparticles available on the market are often dispersed in various stabilizers such as Tweens, PBS or proprietary stabilizers of unknown formulation.
Precise reproducibility of the lots: Consistent nanoparticles properties are essential for meeting regulatory standards in biomedical and pharmaceutical applications. In commercial products, such as lateral flow assays, batch-to-batch variations can affect product performance and reliability. In research, inconsistent nanoparticles properties between batches also affect research validity and can lead to irreproducible results.
Eco-friendly synthesis: Our Green chemistry approach minimizes the use of harsh reagents and reduces the environmental impact of nanoparticle production, aligning with sustainable research practices.
Storage: Store at 4-25grad C away from light - DO NOT FREEZE. Shake the bottle before use.
Expiration: Products can be used for at least one year. If kept longer, measurement of UV-vis spectra is recommended to confirm products stability. Storage at lower temperatures is preferable for increasing the shelf life.
Safety and Handling: NanoBrand does not guarantee the suitability of its products for any particular application. It is the customer’s sole responsibility, prior to use, to determine that the product is suitable and permitted for the customer’s intended use and application. Please consult our Terms and Conditions.
For these nanoparticles products, customized diameters/ concentrations/ surface coatings are available on request.
Share

Download:

Safety Data Sheets
CoA Examples
CoA example 5nm Cold Nano-Spheres citrate.pdf
CoA example 10nm Cold Nano-Spheres citrate.pdf
CoA example 15nm Cold Nano-Spheres citrate.pdf
CoA example 20nm Cold Nano-Spheres citrate.pdf
CoA example 30nm Cold Nano-Spheres citrate.pdf
CoA example 40nm Cold Nano-Spheres citrate.pdf
CoA example 50nm Cold Nano-Spheres citrate.pdf
CoA example 60nm Cold Nano-Spheres citrate.pdf
CoA example 70nm Cold Nano-Spheres citrate.pdf
CoA example 80nm Cold Nano-Spheres citrate.pdf
